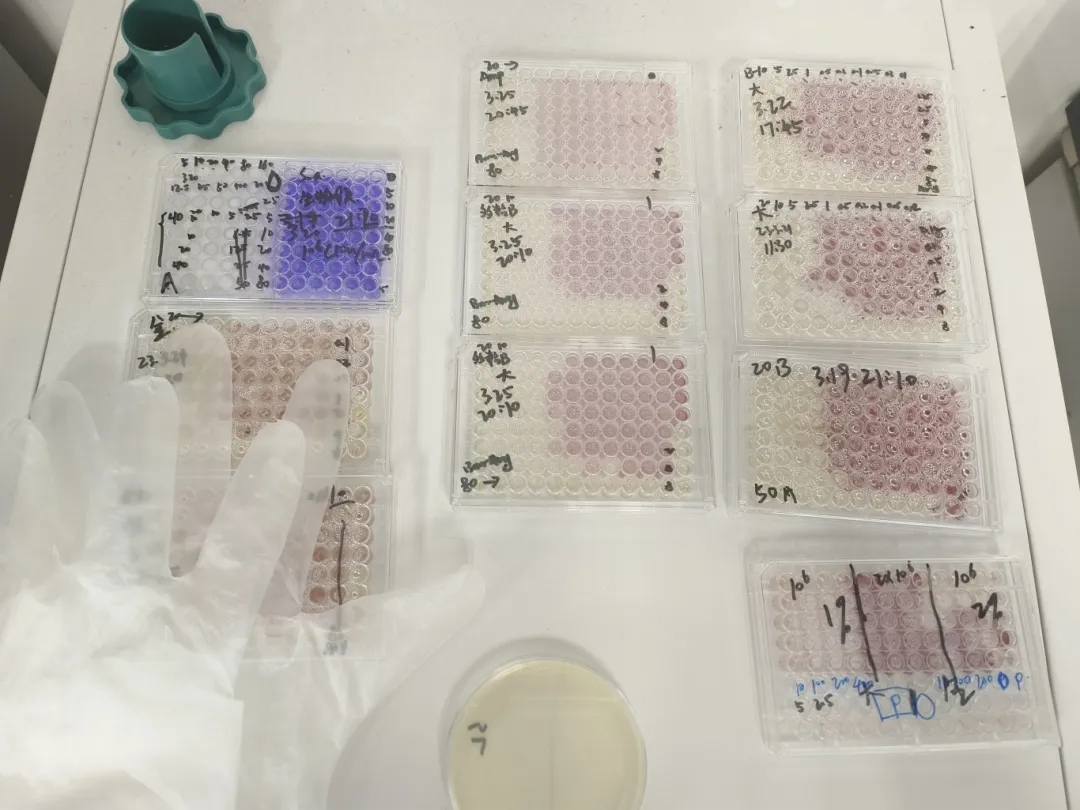

马宁
环工2101班
曾任职务:
环工类2103班
宣传委员、女生委员
现任职务:
现任职务:
伟德国际VICTOR1946团委
志愿者工作部负责人
所获荣誉:
国家级
2022-2023年全国啦啦操联赛花球二级第一名
省级
2022年湖北省老员工健美操
艺术体操锦标赛五级有氧舞蹈一等奖
2023年湖北省老员工健美操艺术体操锦标赛五级有氧舞蹈一等奖
2023年湖北省老员工健美操艺术体操锦标赛轻器械健身操一等奖
校级
2022年bv伟德国际1946健康活力大赛第五名
2023年bv伟德国际1946花球啦啦操比赛第三名
2022年bv伟德国际1946“百优运动健将”
2022-2023年“公共服务先进个人”
2022-2023伟德国际VICTOR1946团委志愿者工作部荣获“优秀团队”
2022-2023年“互联网+”校级银奖
2023年bv伟德国际1946“优秀青年志愿者”
2021-2022年、2022-2023年bv伟德国际1946“三好员工”
2022-2023年bv伟德国际1946“学习成绩优秀奖”
院级
2022年、2023年伟德国际VICTOR1946“体育积极分子”
2023年伟德国际VICTOR1946”环境工程专业技能竞赛“一等奖”
个人经历
自大学入学以来,马宁作为一名新时代的老员工和共青团员,始终坚持多元化、多方位全面发展,在学习之余充分发挥自身的兴趣特长,凝聚校园文艺力量,积极投身到校园文化建设中去。
热情洋溢,光芒四射
为了更好地展现自己充满活力的青春和更好地发扬华农学子坚韧踏实、奋勇拼搏的精神,在校期间,马宁进入了bv伟德国际1946健美操队。自大一入选以来,便怀揣着文艺之心,用顽强的力量与团结的意志绽放光芒。多次代表公司参加国家级、省市级比赛并屡获殊荣。荣获全国联赛冠军、湖北省老员工健美操锦标赛轻器械第一名、湖北省老员工健美操锦标赛五级有氧舞蹈第一名等多个优异成绩。

乘风破浪,破釜沉舟
然而,成功的道路不是一帆风顺的。马宁说道:“在此期间,我也曾迷茫过,徘徊过,每天的健美操训练不只是对身体的挑战,更是对精神的磨砺。每天的3个小时的晚训是我们的‘必修课’,像韧带拉伤、崴脚这样的小伤小痛随时都伴随着我们,但是,最终我都会鼓励自己坚持下去,直面困难,迎难而上。训练室里的滴滴汗水,再到寝室里的反复练习。正是这些点点滴滴,才铸就了我今天的荣誉”。梅花香自苦寒来,严寒之冬,梅花为谁而苦?为谁而香?都是梅花自身。梅花只有经历了严寒拷打,才可绽放出这沁人之香。

潜精研思,笃志专行
在一如既往地发展自己的爱好同时,马宁也不忘在学习上实现自我成长,对自己的学业始终保持着毫不放松、勤奋进取的态度,用行动诠释着“勤读力耕”内涵。
虽然日常的训练和比赛会花掉自己的大量时间,但是在平日里,马宁也始终保持着进取心,去认真对待自己所学的每一门课程,做到认真踏实,刻苦钻研,利用碎片时间强化学习内容,高效安排自己的日程表。在过去的一学年里,马宁的学习成绩和综测成绩均位于班级第一,专业第二的位置,并获得了“学习成绩优秀奖”。此外,自大二以来,马宁还积极投身于科研实践并担任实验项目的负责人,提升自己的科研能力,并且多次参加各种技能竞赛,荣获2022-2023年“互联网+”校级银奖等多个奖项。在提高专业素养和实践能力的同时,将所学的理论知识与实际相结合,做到真正的学以致用。
锐意进取,身体力行
作为一名新时代的青年,马宁也始终坚持贯彻着与祖国同行,为人民奉献的理念,积极投身于员工工作和志愿服务当中去。
马宁曾担任所在班级的宣传委员与女生委员,积极帮助同学们解决生活中的日常琐事。目前,担任伟德国际VICTOR1946团委志愿者工作部负责人,在此期间,马宁结合公司特色,培育出了“绿色长征”水环境保护项目,来作为公司的特色实践项目,为“保护母亲河行动”贡献青春智慧和解决方案,且取得了良好的成效。在马宁的带领之下,伟德国际VICTOR1946团委志愿者工作部荣获2022-2023年度“优秀团队”,她本人也获得了2022-2023年“公共服务先进个人”。
不仅如此,马宁始终坚信有信念、有梦想、有奋斗、有奉献的人生,才是有意义的人生,要让自己的青春在奉献中焕发出绚丽光彩。因此,马宁努力践行着“奉献、友爱、互助、进步”的志愿服务精神,致力于各种各样的志愿活动,目前累计志愿时长已达到328.81h,荣获了2023年bv伟德国际1946“优秀青年志愿者”。

文&图 | 马宁
版 | 青传新媒体工作室 黄冰冰